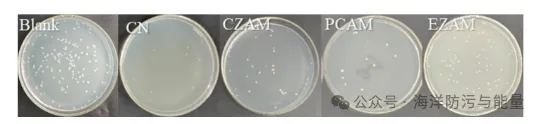

海洋污垢是指海洋生物在船舶和海洋设施上的有害积累,是人类开发利用海洋过程中面临的重大挑战,它会导致船舶燃油消耗增加、海底管道堵塞、海洋仪表设施损坏等。应用海洋防污涂料被认为是解决海洋生物污损问题最经济有效的方法,有机锡防污涂料虽然具有高效防污性能,但由于有机锡防污涂料有显着毒性被禁用。基于有机锡防污涂层的防污机制,研究者开发出无锡自抛光防污涂层,但其依赖高含量的铜氧化物实现防污,对海洋环境造成潜在危害。因此,树脂在防污涂层中的功能性需要得到提升。 基于单一功能树脂的防污涂料具有自抛光、低表面能等功能,但防污性能仍不理想,因此,通过树脂的多功能协同作用来提高防污性能是当前该领域研究开发的热点。荧光防污是利用物质的荧光驱避作用来防止生物附着和污损的方法。荧光可以改变硅藻叶绿体形态,有效抑制涂层表面的堆积和沉降,从而有助于海洋生物污垢的早期防治。此外,在透明海水中,紫外线可以穿透达20 m,使得荧光防污成为可能。 研究者合成了三种含碳碳双键的咔唑酰胺衍生物,并以此为功能单体制 备了含有咔唑衍生结构的丙烯酸锌树脂。还研究了该树脂的防污性能,为开发环保型海洋防污材料提供了理论依据。 论文发表在期刊《Chemical Engineering Journal》。 含咔唑衍生物结构的丙烯酸锌树脂的合成 研究者合成了如图一所示的三种咔唑衍生物。将配备有搅拌器的三颈烧瓶置于油浴中并添加无水乙醇作为溶剂。将0.1 mol咔唑和0.12 mol N-羟甲基丙烯酰胺,依次分散在一定量的溶剂中。搅拌1小时后,将浓硫酸(10mL)滴加至三颈烧瓶中。反应在40°C下进行72小时,直至获得固体产物。过滤沉淀的产物,并用去离子水洗涤过滤的固体至pH 7。通过用无水乙醇重结晶纯化粗产物,得到CZAM。参照CZAM合成PCAM和ECAM。 图1.咔唑衍生物的结构式:A. CZAM B. PCAM C. ECAM 将三颈烧瓶置于油浴中,加入溶剂二甲苯和正丁醇(二甲苯:正丁醇=4:1,wt%),升温至85°C,然后每隔15分钟加入丙烯酸单体、咔唑衍生物和偶氮二乙丁晴。然后将反应体系在85°C下保持4小时以获得预聚物,并在整个过程中保持回流。最后,将氧化锌、苯甲酸以及溶剂二甲苯、正丁醇和乙酸丁酯加入三颈烧瓶中,并在85°C下反应4小时。获得了含有咔唑衍生结构的丙烯酸锌树脂。 图2.含有咔唑衍生物结构的丙烯酸锌树脂的合成示意图 咔唑衍生物的荧光强度测试 称取一定量的咔唑衍生物,溶解于DMSO中,分别稀释至1×10-5 mol/L,用荧光分光光度计测定荧光发射光谱。狭缝宽度EX/EM=2.5 nm,扫描电压=700 V。 PCAM具有最高的荧光强度,ECAM次之,CZAM最弱,但其荧光强度仍超过2000。因此,三种化合物均具有良好的荧光性。 图3.咔唑衍生物的荧光发射光谱 咔唑衍生物的抗菌试验 选择海洋假交替单胞菌作为测试菌株。将海洋假交替单胞菌置于37°C恒温培养箱中24小时。将活化后的细菌用接种环接种到2216E液体培养基中,然后在恒温培养箱中培养24h。用紫外可见分光光度计将菌悬液稀释至合适浓度,然后向菌悬液中加入一定量的复合溶液,置于恒温振荡培养箱中培养24 h。将培养的菌悬液用生理盐水(9 g/L)稀释10倍,然后将0.2 mL菌液吸附在2216 E固体培养基上。用三角涂棒将菌液均匀涂于固体培养基表面,直至完全吸收,然后将固体培养基置于37°C恒温培养箱中培养24 h。 图4显示了咔唑衍生物对海洋细菌的抑制作用,其中CN是广谱杀菌剂百菌清,对细菌具有更大的毒性。在三个实验组中,PCAM 的抗菌率为 90%,与CN相当。这源于PCAM含有两个酰胺基,具有很高的化学活性,从而 对细菌的生长和繁殖产生明显的抑制作用。CZAM的抑菌率为80%,ECAM的抑菌率最低;然而,与空白对照相比,ECAM仍然表现出可测量的抑菌效果。实验结果表明,三种咔唑衍生物对海洋假单胞菌具有明显的抑制作用。 图4.咔唑衍生物的抑菌图 咔唑衍生物抑藻试验 选择三角褐指藻和新月菱形藻作为测试藻种。首先将指数生长期的藻种依次稀释,在最大吸收波长处测定吸光度。通过血细胞计数板测定藻类浓度。以吸光度为横坐标,浓度为纵坐标,绘制标准工作曲线。将培养至指数生长期的藻液稀释至合适浓度,量取稀释后的藻液100ml于锥形瓶中,移取1ml(1.5mg/ml)咔唑衍生物溶液加入锥形瓶中,混合均匀。以不含供试化合物的藻液作为空白对照,每24 h测定各藻液在最大吸收波长处的吸光度值。根据藻类吸光度值浓度的线性关系绘制时间‐藻类浓度曲线。培养箱内的光照强度为4000 lx,明暗比为14:10,温度为21°C。使用的海水通过砂芯漏斗过滤并在高压灭菌器中灭菌(121°C)。 图5数据表明,CN对三角褐指藻和新月菱形藻的生长抑制效果最为显着抑制率为86%。CZAM对三角褐指藻的生长抑制率最高,达到81%,抑制效果与CN相当。PCAM的抑藻性能弱于CZAM,这是因为PCAM的溶解性较差,对抑藻率造成一定的影响。三种咔唑衍生物对这两种藻类的抑制率均在70%以上,表明它们具有良好的抑藻性能。 图5.咔唑衍生物第7天对微藻的抑制率 含咔唑衍生物的丙烯酸锌树脂的红外光谱 图6中可以看出,‐NH‐的伸缩振动吸收峰在3413 cm -1处,‐CH3和‐CH2的伸缩振动吸收峰在2961 cm-1和2873 cm -1处。羧酸中的羰基在1735 cm -1处有一个伸缩振动吸收峰,‐COO‐Zn‐COO‐的伸缩振动吸收峰在1608 cm -1处。1571 cm -1和1501 cm-1是芳香烃的振动峰,对称和不对称伸缩峰。–COO‐的振动吸收峰分别位于1240 cm-1和1025 cm-1处。这表明在丙烯酸锌树脂中引入了咔唑衍生物。719 cm-1处是Zn‐O的伸缩振动吸收峰。由此,成功合成了含有咔唑衍生结构的丙烯酸锌树脂。 图6.普通丙烯酸锌树脂与含有咔唑衍生物结构的丙烯酸锌树脂的IR对比 含咔唑衍生物结构的丙烯酸锌树脂的荧光强度 两种树脂的荧光发射光谱如图7所示,与含有CZAM的树脂相比, 掺入PCAM的树脂表现出更高的荧光强度,这与各自化合物固有的荧光特性一致。对两种树脂的荧光强度变化进行分析,发现它们的荧光强度随着咔唑衍生物结构含量的增加而增加,表现出很强的规律性。 图7.含有咔唑衍生物结构的丙烯酸锌树脂的荧光强度 含咔唑衍生物结构的丙烯酸锌树脂抑藻 图8为含咔唑衍生物结构的丙烯酸锌树脂与普通丙烯酸锌树脂(对照)。在太阳光/暗交替条件和培养箱光/暗交替条件下两种实验条件下对三角褐指藻和新月菱形藻的抑藻性能结果。从结果可以看出,在培养箱明/暗交替条件下,实验组的抑藻率显着高于对照组,最高达到88.5%。这一结果清楚地证明了荧光功能结构的引入显着增强了树脂的化学排斥性 且抑藻效果随着荧光功能单体含量的增加而增强。 阳光明暗交替条件下的抑藻率略低于培养箱明暗交替条件下的抑藻率。这可能是因为藻类在自然光条件下倾向于进行更多的光合作用,从而具有更高的繁殖率,而化合物的化学活性没有变化,导致自然光条件下的藻类抑制率相对较低。 不同树脂比较,CZ树脂的抑藻率高于PCZ树脂。这是因为树脂的抑藻效果受到化合物的荧光和化学活性的影响。虽然CZ树脂的荧光强度不如PCZ强,但CZ树脂中CZAM的分子量较小,渗透性较高,更容易进入藻细胞内部,破坏细胞器,因此其抑制率比PCZ树脂高。 图8.涂层对微藻的抑制率:A.三角褐指藻B.新月菱形藻 含咔唑衍生物结构的丙烯酸锌树脂的防藻附着 从图9(A)可以看出,在培养箱明/暗交替条件下,实验组树脂表面新月菱形藻附着量明显小于对照组,抗粘连率最大可增强83.52%。从图9(B)可以看出,实验组树脂的抗粘附率较对照组提高了74.18%,证明引入咔唑衍生物后树脂的化学驱抗藻沉降和粘附性能显着。日光明暗交替条件下树脂表面叶绿素(a)含量明显低于培养箱明暗交替条件下的叶绿素(a)含量,且随着荧光功能单体含量的增加,叶绿素(a)的减少量增加,对三角褐指藻和新月菱形藻的附着抑制率最大可提高91.43%和97.37%。分别。PCZ‐6在阳光/黑暗交替条件下荧光强度最高,抗粘附性能最好,与培养箱明/暗条件相比,树脂的抗藻附着率最大提高了47.27%,这表明树脂的荧光排斥效应除了化学排斥效应外,也是树脂优异的抗藻沉积粘附性能的重要因素。 图 9. 沉积在涂层表面的藻类的叶绿素 (a) 含量:A. 三角褐指藻 B. 新月菱形藻 含咔唑衍生物结构的丙烯酸锌树脂对藻类光合色素的影响 从图10可以看出,三角褐指藻中光合色素的含量在太阳光/黑暗交替条件下比在培养箱光/黑暗交替条件下稍高。这种差异可能是由于树脂在自然光条件下发出更强的荧光,这可能促进藻类的光合作用,导致光合色素的减少较小。 进一步分析表明,引入咔唑衍生物结构后,实验组三角褐指藻中叶绿素(a)、叶绿素(c)和类胡萝卜素的含量无论在培养箱光照还是阳光/黑暗条件。在类胡萝卜素中,树脂CZ对类胡萝卜素的影响最为显着,在培养箱光/暗交替条件下和太阳光/黑暗交替条件下,树脂CZ分别降低了80.77%和77.34%。在培养箱明/暗交替条件下,树脂 ECZ对叶绿素(a)含量的影响也相当大,对照相比降低了49.46%。培养箱光照条件下的抑藻实验和光合色素含量影响实验结果表明,树脂中的咔唑衍生结构具有良好的化学活性,能有效抑制藻类的生长和附着。该树脂在太阳光条件下的抑藻性能弱于培养箱光照条件,而抗藻沉积性能则明显优于培养箱光照条件,初步证明咔唑衍生结构的强荧光特性使藻类倾向于光合作用而不是选择性沉降,因而有利于防止藻类污染。 图10.三角褐指藻光合色素含量A.叶绿素 (a) B.叶绿素(c) C.类胡萝卜素 含咔唑衍生物结构的丙烯酸锌树脂对藻细胞形态的影响 含咔唑衍生物结构的丙烯酸锌树脂对三角褐指藻生长的实验可以观察到,实验前,对照组A的三角褐指藻细胞呈现典型的梭形形态,且细胞饱满,细胞壁完整。实验处理后,实验B组藻细胞形态出现皱纹,细胞膜受损,部分细胞甚至出现严重破损、死亡。结果表明,咔唑衍生物中的酰胺基可能导致藻细胞Ca2+外流,进而损伤细胞壁,是造成细胞损伤的主要原因。 图11.抑藻试验后藻细胞表面形态 图12显示了动态桨动中树脂的质量损失。实验进行三十天后,树脂的磨损率更大。其原因有三:一是树脂中残留的溶剂和小分子量单体的释放,二是亲水基团的水解和对树脂表面的抛光作用,三是树脂之间的离子交换作用。随着实验的进行,树脂的磨损率趋于稳定。值得注意的是,CZ、PCZ、ECZ树脂的磨损率明显低于对照组,说明咔唑酰胺化合物的引入提高了树脂的稳定性,降低了树脂的磨损率,可以延长树脂的防污期效果。 图12.涂层质量磨损率的变化 含咔唑衍生物结构的丙烯酸锌树脂海洋防污性能测试 如图13所示,经过60天的实海防污性能测试,对照组表面出现大量藻类等生物污损,表明生物污损相当严重。实验组中,随着咔唑衍生物结构含量的增加,污垢生物的附着力显着下降,特别是当咔唑衍生物结构含量为6%时。经过120天的实海防污试验,涂层仍保持优异的防污性能,咔唑衍生物结构含量为6%的涂层表面仅有少量的污损生物和污泥。实验结果表明,咔唑衍生物结构的引入可以显着提高丙烯酸锌树脂的海洋防污性能。 图13.涂层海上挂板图片:A.60天 B.120天 防污机理 该树脂的防污机理如图14所示。首先,在抗藻类沉降附着实验中, 自然光条件下的抗藻类附着率比培养箱光照条件下高47.27%。这表明荧 光功能结构通过干扰藻细胞叶绿体的空间结构来抑制下沉附着,使藻类 更倾向于光的作用,从而起到荧光驱避剂的作用。 另外,在树脂抑藻实验中,树脂对藻类生长的抑制率达到88.5%。结合抑藻实验前后藻细胞表面的扫描电镜图像,证明含有咔唑衍生物结构的丙烯酸锌树脂能够促进藻细胞内Ca2+的流出,抑制细胞壁的合成。在树脂对藻类光合色素作用的实验中,藻类细胞中类胡萝卜素的含量下降了80.77%,证明树脂抑制了藻类细胞光合色素的合成。因此,树脂起到了化学避免作用。最后,在自抛光实验中,树脂可以将侧链上的金属基团与海水中的Na+和Mg2+进行交换,并溶解亲水基团,实现在恒定水流下涂层表面的不断更新,使得附着的污损生物在海水的侵蚀下逐层从树脂上剥离,有效降低了污损生物的粘附。 图14.涂层防污机理示意图
免责声明:本网站所转载的文字、图片与视频资料版权归原创作者所有,如果涉及侵权,请第一时间联系本网删除。
官方微信
《腐蚀与防护网电子期刊》征订启事
- 投稿联系:编辑部
- 电话:010-62316606
- 邮箱:fsfhzy666@163.com
- 腐蚀与防护网官方QQ群:140808415